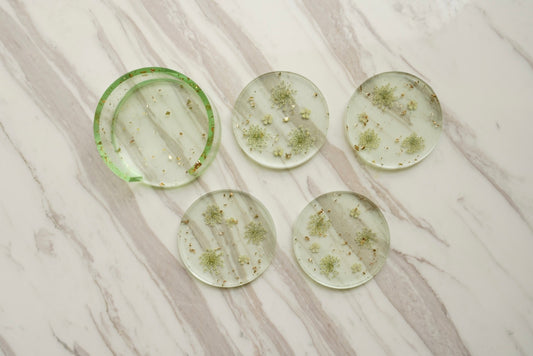
'VERDANT WALTZ' Coaster Set (Set of 4)

Collection: Products
-
 Sold out
Sold out'Thank You' Card with「CHINA ROSE」
Regular price $9.99 CADRegular price$12.99 CADSale price $9.99 CADSold out -
'VERDANT WALTZ' Coaster Set (Set of 4)
Regular price $35.00 CADRegular price -
'WINTER MOON' Coaster Set (Set of 4)
Regular price $35.00 CADRegular price -
BLUEBIRD Keychains (Set of 2)
Regular price $19.99 CADRegular price -
BLUSH TWILIGHT Phone Case
Regular price $32.00 CADRegular price -
CARMEN Keychains (Set of 3)
Regular price $19.99 CADRegular price -
CONSTELLATION Bookmark
Regular price $7.50 CADRegular price -
DAISY GLOW Phone Case
Regular price $32.00 CADRegular price -
DAISY OF THE SUN Keychains (Set of 2)
Regular price $19.99 CADRegular price -
GOLDEN HOUR Bookmark
Regular price $7.50 CADRegular price -
GOLDEN MEADOW Phone Case
Regular price $32.00 CADRegular price -
Greeting Cards with「Blue Larkspur」
Regular price $9.25 CADRegular price$0.00 CADSale price $9.25 CAD